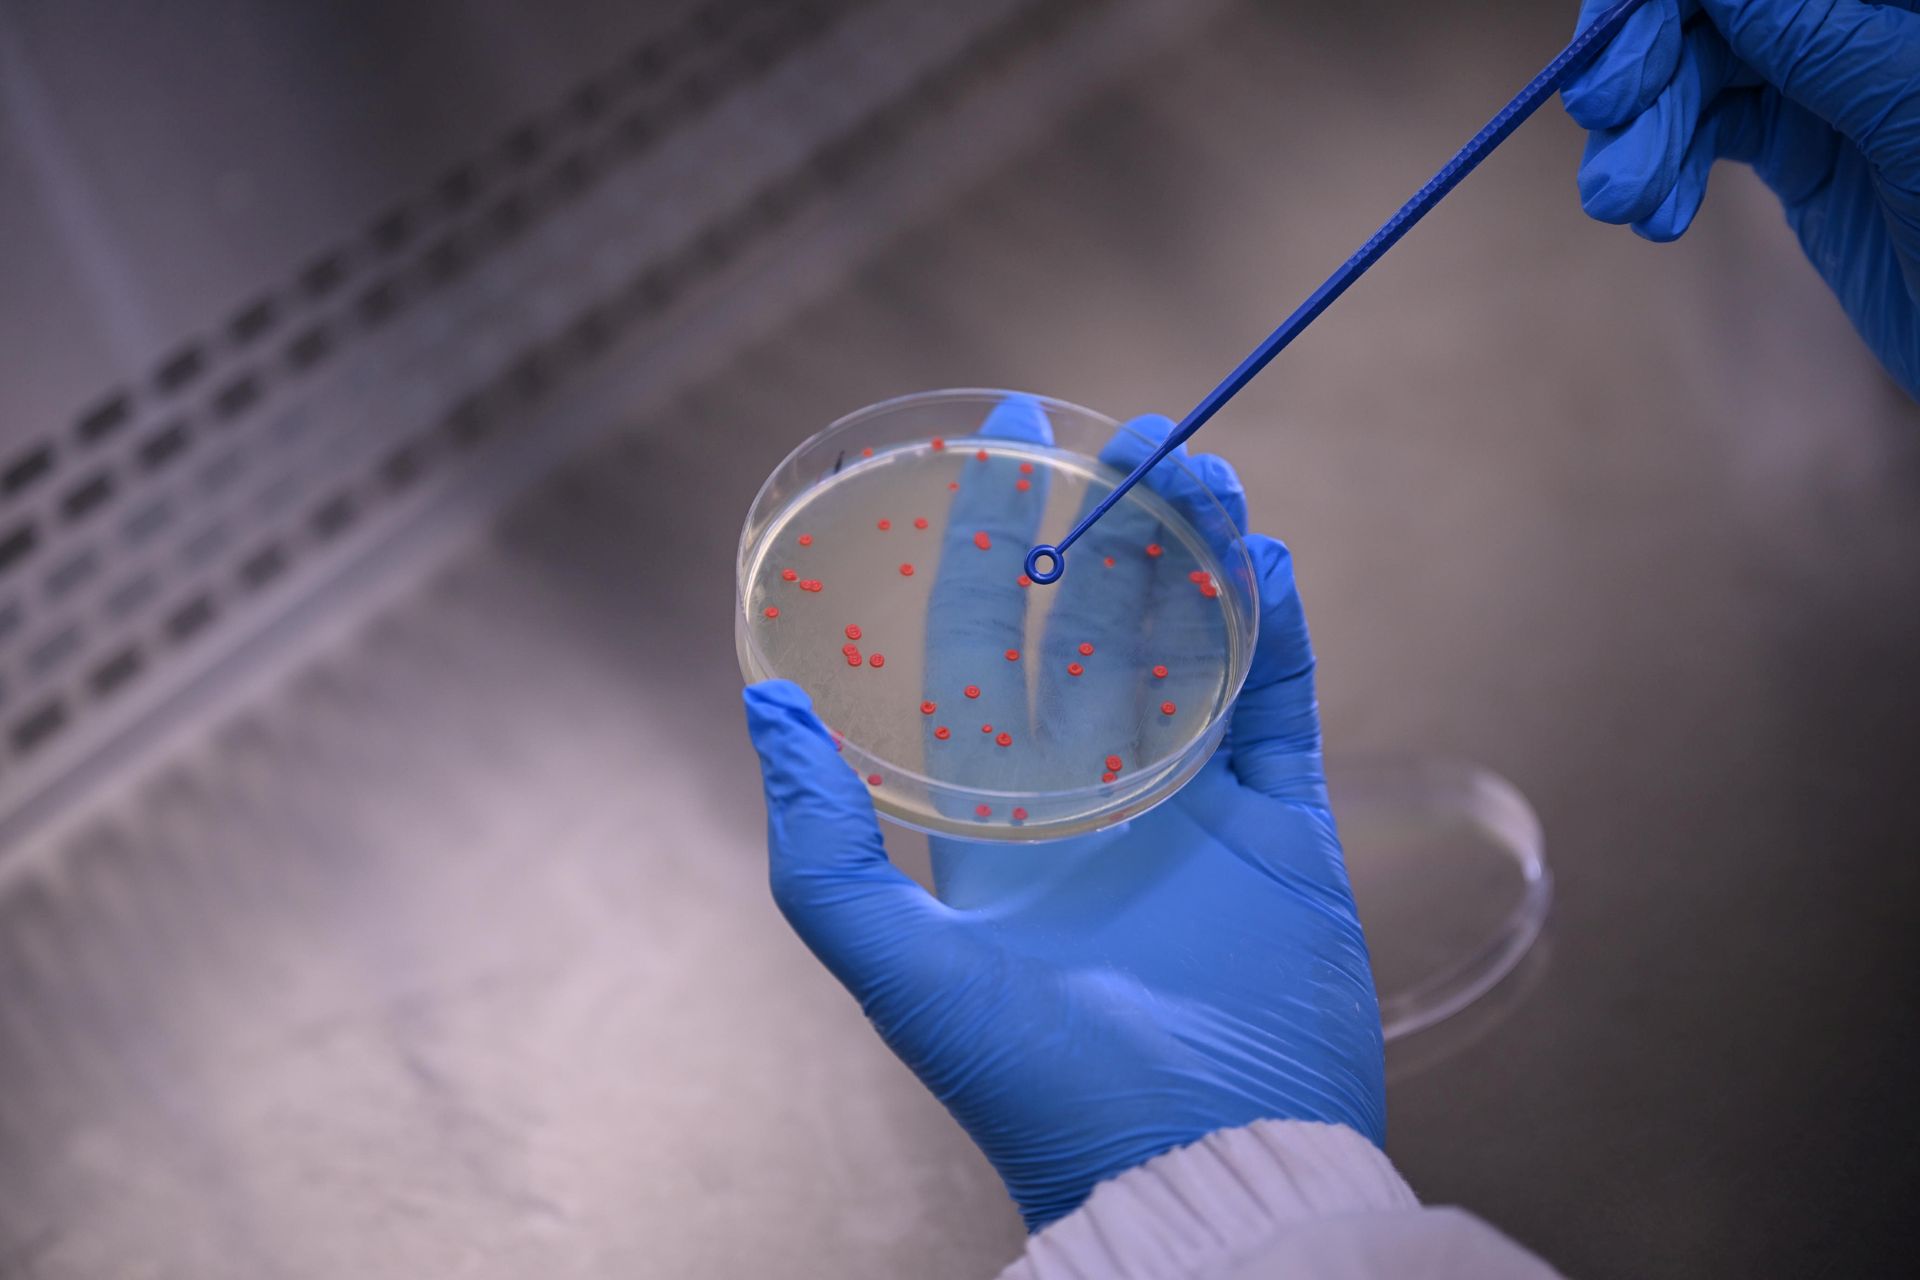
Pärm Rhodontula toruloides laboris

The strikingly orange yeast Rhodotorula toruloides is already known for its ability to produce valuable oils and pigments. Researchers from TalTech uncovered a new talent for this yeast: manufacturing sugar-based polymers that could replace synthetic materials with more sustainable, bio-based alternatives.
Microbial cell factories are used in biotechnology to produce valuable biochemicals for medicine, food, and sustainable materials. Yeasts are one of the most important cell factories due to their robust ability to grow on plant sugars while producing high-value compounds, making our planet less dependent on fossil fuels.
R. toruloides is well known for its ability to produce oils and carotenoids (vitamin A precursors) within its cells, where these compounds naturally accumulate as part of its metabolism. Recently, researchers at the Department of Chemistry and Biotechnology identified the mechanism by which this yeast can also produce biopolymers.
Seeking to explore the yeast’s additional biotechnological potential, scientists investigated its behaviour under stress conditions. Yeasts are often studied under stress because changes such as acidity, salinity, temperature shifts, or nutrient limitation force them to reprogram their metabolism and produce protective or storage compounds that are rarely formed under normal growth conditions, revealing hidden metabolic potential.
While studying the effects of salt stress on yeasts, scientists noticed that R. toruloides cells which normally float freely as individual cells in the solution, tended to form sticky clumps, or aggregates, under certain conditions. The clumping indicated that the yeast is altering its surface properties to cope with environmental pressures.
However, one of the authors of the study, Senior Researcher Rahul Kumar, explains that the team was surprised to observe the opposite effect when simple salts were added: „Adding sodium or potassium chloride prevented clumping instead. We suspected that something more complex was happening on the yeast’s surface - that the cells were actively producing and releasing biomolecules that changed their surface properties, rather than just passively enduring the excess salt”.
Research led to the discovery that R. toruloides can synthesize and export exopolysaccharides (EPS), complex sugar-based biopolymers. From here, the team developed methods for identification and characterization of those biopolymers, which are known for their gelling, protective, or adhesive properties, often with significant industrial potential. Under controlled nutrient conditions, the yeast produced significant amount of EPS - up to 6 grams per litre.
Another key finding was the link between EPS production and an acidic environment. In acidified conditions, the secretion of the biopolymer is promoted, shaping the extracellular environment. As co-author of the study, PhD student, Henrique Hamacek explains, “What we found particularly intriguing was how closely EPS production was linked to acidity. This means that adjusting the yeast’s environment can initiate the production of these valuable polymers.” Using bioinformatics, the team also identified the genetic blueprints that could explain the molecular machinery of this process.
Rahul Kumar is hopeful that this research will expand the biotechnological potential of R. toruloides beyond its well-known lipid and carotenoid production, and open new paths for developing sustainable, microbial-based materials . These findings indicate that this yeast can be engineered to produce other extracellular biomolecules, overcoming bioprocess bottlenecks of recovering intracellular products, possibly making it a valuable cell factory in the future.
Results were published at the Applied and Environmental Microbiology journal.